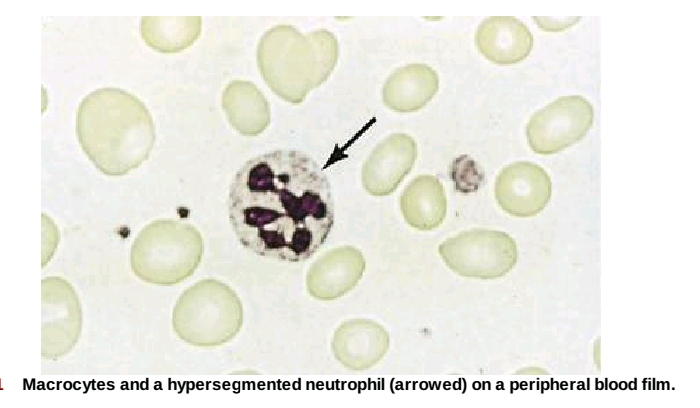

Causes of macrocytosis
Macrocytosis with megaloblastic changes in bone marrow
- Vitamin B12 deficiency or abnormal vitamin B12 metabolism
- Folic acid deficiency or abnormal folate metabolism
- Other defects of DNA synthesis, such as congenital enzyme deficiencies in DNA synthesis (e.g. orotic aciduria), or those resulting from therapy with drugs interfering with DNA synthesis (e.g. hydroxycarbamide (hydroxyurea), azathioprine)
- Myelodysplasia due to dyserythropoiesis
Macrocytosis without megaloblastic changes in bone marrow
(In all these conditions, normal levels of vitamin B12 and folate will be found)- Physiological: During pregnancy and in newborn
- Alcohol excess
- Liver disease
- Reticulocytosis (e.g. due to haemolysis)
- Hypothyroidism
- Some haematological disorders (e.g. aplastic anaemia, myelodysplasia, pure red cell aplasia, multiple myeloma)
- Drugs (e.g. hydroxycarbamide, azathioprine)
- Cold agglutinins due to autoagglutination of red cells (the MCV decreases to normal with the warming of the sample to 37°C)
[Source: Kumar and Clark's Clinical Medicine 9th Edition: 526 & 530]

0 Comments